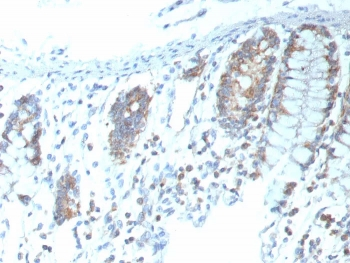
CD151 Antibody

You have no items in your shopping cart.
Search results for: 'CD151'
- Recombinant CD151 Antibody [orb2317413]
IHC
Human
Rabbit
Monoclonal
Unconjugated
100 μg (without BSA and Azide), 20 μg, 100 μg - Human CD151 Polyclonal Antibody [orb2951452]
ELISA, IHC, WB
Human
Rabbit
Polyclonal
Unconjugated
100 μg, 50 μg - Recombinant Human CD151 Protein, N-GST & C-His [orb2962993]
>90% as determined by SDS-PAGE.
40.64 kDa
1 mg, 100 μg, 50 μg - Recombinant Human CD151 Protein, N-His [orb2968478]
>90% as determined by SDS-PAGE.
21.10 kDa
1 mg, 100 μg, 50 μg - Recombinant Human CD151 Protein, N-Fc [orb2966398]
>90% as determined by SDS-PAGE.
40.3 kDa
1 mg, 100 μg, 50 μg